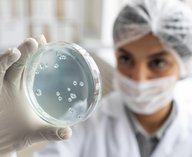
бактерии, опухоли, наука

Meta* представила план по обеспечению прозрачности и противодействию вмешательству в ходе промежуточных выборов в США, которые пройдут в ноябре. Компания заявила, что продолжит работу по предотвращению иностранного вмешательства и мониторингу возможных угроз в режиме реального времени.
В Meta* заявили, что за последние десять лет направили более 30 млрд долларов на безопасность и защиту платформ, включая меры по защите выборов.
Компания сохранит обязательную авторизацию для рекламодателей, размещающих политическую рекламу или объявления по общественно значимым вопросам. Такие объявления должны содержать отметку об источнике финансирования, их будут хранить в открытой библиотеке рекламы в течение семи лет. В американском сегменте библиотеки уже насчитывается более 18 млн объявлений.
За неделю до дня голосования компания заблокирует размещение новых политических и социальных рекламных объявлений. При этом реклама, получившая хотя бы один показ до начала ограничительного периода, сможет продолжить размещение.
Meta* также обязала рекламодателей раскрывать использование искусственного интеллекта при создании или изменении политической рекламы в ряде случаев. Компания планирует самостоятельно выявлять и маркировать контент, созданный с помощью ИИ, и применять санкции к материалам с фотореалистичными видео или аудио, созданными цифровыми средствами.
Кроме того, в преддверии выборов пользователи Facebook** и Instagram** получат уведомления с информацией о регистрации и участии в голосовании.
*— запрещена в России
** — принадлежат запрещенной в России Meta
Фото: Rob Dobi